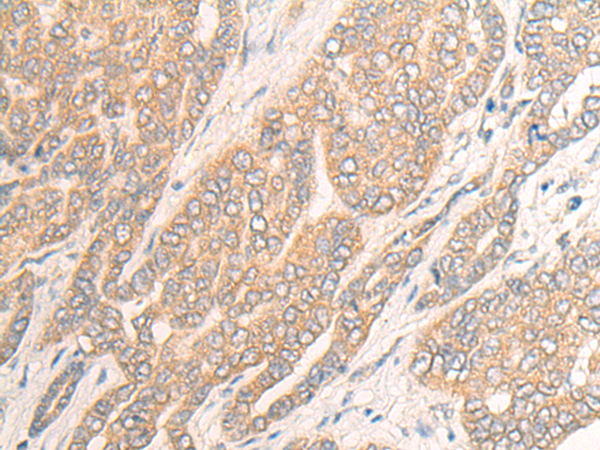

|
Background: |
ATP-dependent RNA helicase involved in mRNA export from the nucleus. Rather than unwinding RNA duplexes, DDX19 functions as a remodeler of ribonucleoprotein particles, whereby proteins bound to nuclear mRNA are dissociated and replaced by cytoplasmic mRNA binding proteins (By similarity). |
|
Applications: |
ELISA, IHC |
|
Name of antibody: |
DDX19A |
|
Immunogen: |
Fusion protein corresponding to a region derived from 279-478 amino acids of human DDX19A |
|
Full name: |
DEAD-box helicase 19A |
|
Synonyms: |
DDX19L; DDX19-DDX19L |
|
SwissProt: |
Q9NUU7 |
|
ELISA Recommended dilution: |
5000-10000 |
|
IHC Positive control: |
Human liver cancer;Human esophagus cancer |
|
IHC Recommended dilution: |
20-100 |

購物車
購物車 幫助
幫助
 021-54845833/15800441009
021-54845833/15800441009
